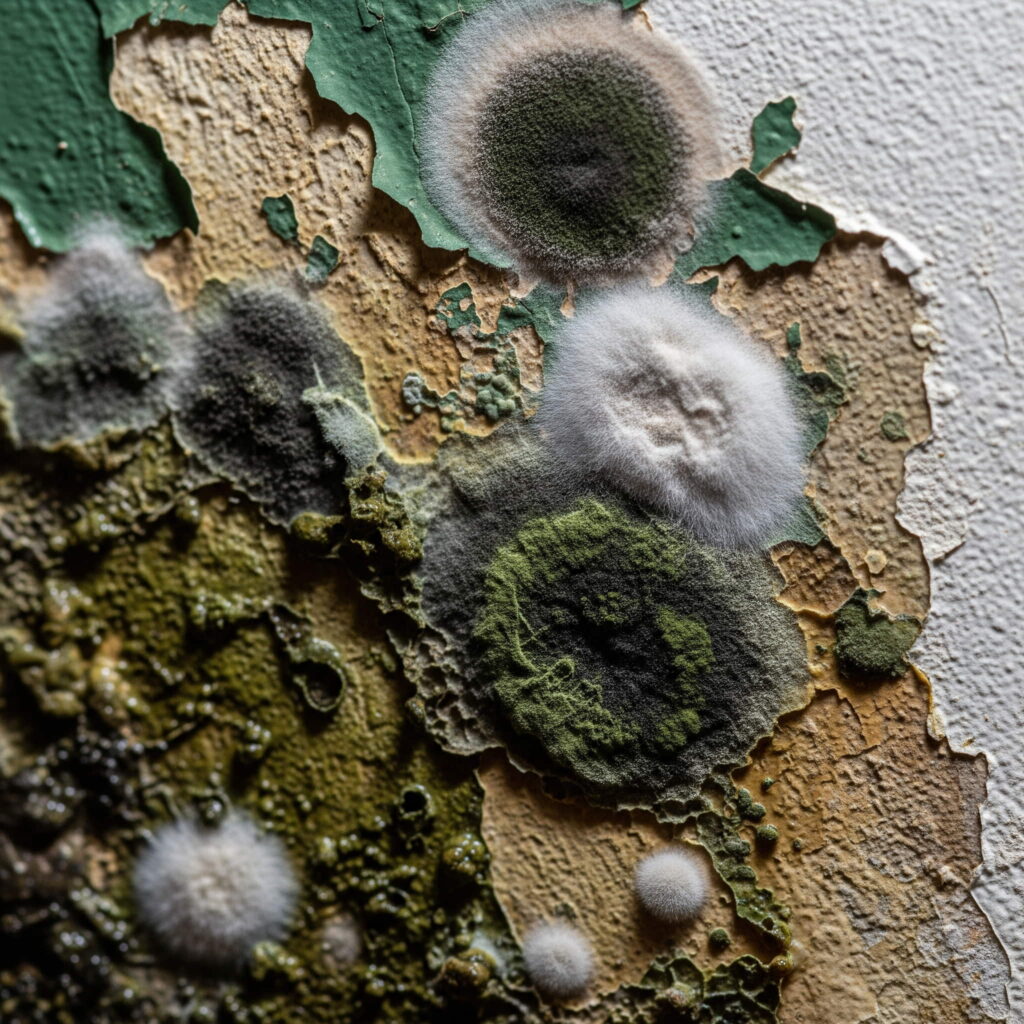

¿Tienes moho en las paredes? Descubre por qué aparece, los riesgos que implica y cómo eliminarlo de forma definitiva con soluciones efectivas y seguras.
¿Qué es el moho en las paredes y por qué debería preocuparte?
El moho en las paredes no es solo una molestia estética: también representa un serio problema de salud y un signo claro de humedad en tu hogar. Este hongo microscópico prolifera en ambientes húmedos y mal ventilados, causando manchas negras o verdosas que pueden empeorar con el tiempo si no se tratan correctamente.
¿Por qué aparece el moho en las paredes?
Existen varias causas comunes por las que puede salir moho en las paredes:
1. Humedad por condensación
Ocurre cuando el vapor de agua en el aire se condensa sobre superficies frías, como paredes mal aisladas.
2. Filtraciones de agua
Pequeñas grietas en techos o paredes permiten que la humedad exterior se filtre, creando el ambiente perfecto para el moho.
3. Fugas internas
Tuberías con fugas dentro de la pared pueden mantenerla constantemente húmeda, alimentando la proliferación del moho.
4. Falta de ventilación
Baños, cocinas o habitaciones cerradas sin ventilación adecuada acumulan humedad, especialmente en climas fríos o lluviosos.
Riesgos de convivir con moho en casa
Vivir con moho en las paredes puede tener consecuencias serias:
- Alergias, irritación en ojos y garganta
- Problemas respiratorios, especialmente en niños o personas asmáticas
- Olor a humedad persistente
- Daño estructural a las paredes
Por eso, actuar rápidamente es clave para evitar que el problema empeore.
Cómo eliminar el moho de las paredes para siempre
Eliminar el moho no es solo limpiarlo superficialmente. Para deshacerte de él de manera definitiva, sigue estos pasos:
1. Identifica y elimina la fuente de humedad
- Repara goteras o fugas
- Mejora la ventilación natural o instala extractores
- Usa deshumidificadores si vives en zonas húmedas
2. Limpia la zona afectada correctamente
Materiales necesarios:
- Guantes y mascarilla
- Cepillo o esponja
- Agua y vinagre blanco, bicarbonato o productos antimohos
- Pintura antihumedad (opcional para acabado final)
Paso a paso:
- Usa una mezcla de vinagre con agua caliente o un producto específico contra moho.
- Frota la zona afectada con un cepillo o esponja.
- Enjuaga con agua limpia y seca completamente.
- Aplica pintura antihumedad para prevenir futuros brotes (si lo deseas).
3. Prevención a largo plazo
- Ventila habitaciones diariamente
- Evita secar ropa dentro de casa
- Aísla térmicamente las paredes si es necesario
- Instala sensores de humedad
¿Cuándo llamar a un profesional?
Si el moho ha invadido una gran parte de tus paredes o si regresa una y otra vez pese a tus esfuerzos, lo mejor es contactar con un especialista en humedad y moho. Ellos cuentan con herramientas para detectar el origen exacto del problema y ofrecer una solución definitiva.
Di adiós al moho en tus paredes
El moho en las paredes no solo es desagradable a la vista, sino también peligroso para tu salud y la de tu familia. Afortunadamente, con una correcta limpieza y medidas preventivas, puedes eliminarlo para siempre. No ignores las señales: actuar a tiempo marcará la diferencia.
¿Tienes problemas de humedad en casa?
Déjame ayudarte. Comenta abajo o comparte este artículo con alguien que necesite una solución definitiva contra el moho.
